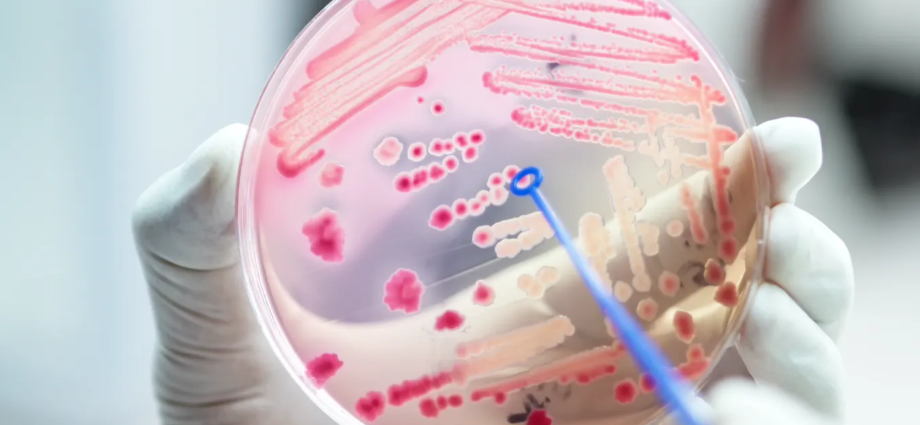

André O. Hudson, Rochester Institute of Technology; Fidelma Fitzpatrick, RCSI University of Medicine and Health Sciences; Juliana Côrrea, Escola de Administração de Empresas de São Paulo da Fundação Getúlio Vargas (FGV/EAESP); Lori L. Burrows, McMaster University; Raúl Rivas González, Universidad de Salamanca; Roy Robins-Browne, The University of Melbourne, and Yori Yuliandra, Universitas Andalas
October 16, 2023
Almost since antibiotics were first discovered, we’ve been aware bacteria can learn how to overcome these medicines, a phenomenon known as antimicrobial resistance.
The World Health Organization says we’re currently losing to the bugs, with resistance increasing and too few new antibiotics in the pipeline.
We wanted to know whether experts around the world think we will still have effective antibiotics in 50 years. Seven out of seven experts said yes.

André O. Hudson, Dean of the College of Science, Professor of Biochemistry, Rochester Institute of Technology; Fidelma Fitzpatrick, Consultant Microbiologist, Beaumont Hospital, Dublin, Ireland and Professor and Head of Department, Clinical Microbiology, RCSI University of Medicine and Health Sciences; Juliana Côrrea, Pesquisadora de pós-doutorado em saúde pública, Escola de Administração de Empresas de São Paulo da Fundação Getúlio Vargas (FGV/EAESP); Lori L. Burrows, Professor of Biocchemistry and Biomedical Sciences, McMaster University; Raúl Rivas González, Catedrático de Microbiología. Miembro de la Sociedad Española de Microbiología., Universidad de Salamanca; Roy Robins-Browne, Honorary Professorial Fellow, medical microbiology, The University of Melbourne, and Yori Yuliandra, Associate Professor of Pharmaceutical Sciences, Universitas Andalas
Subscribe to our newsletter.
This article is republished from The Conversation under a Creative Commons license. Read the original article.